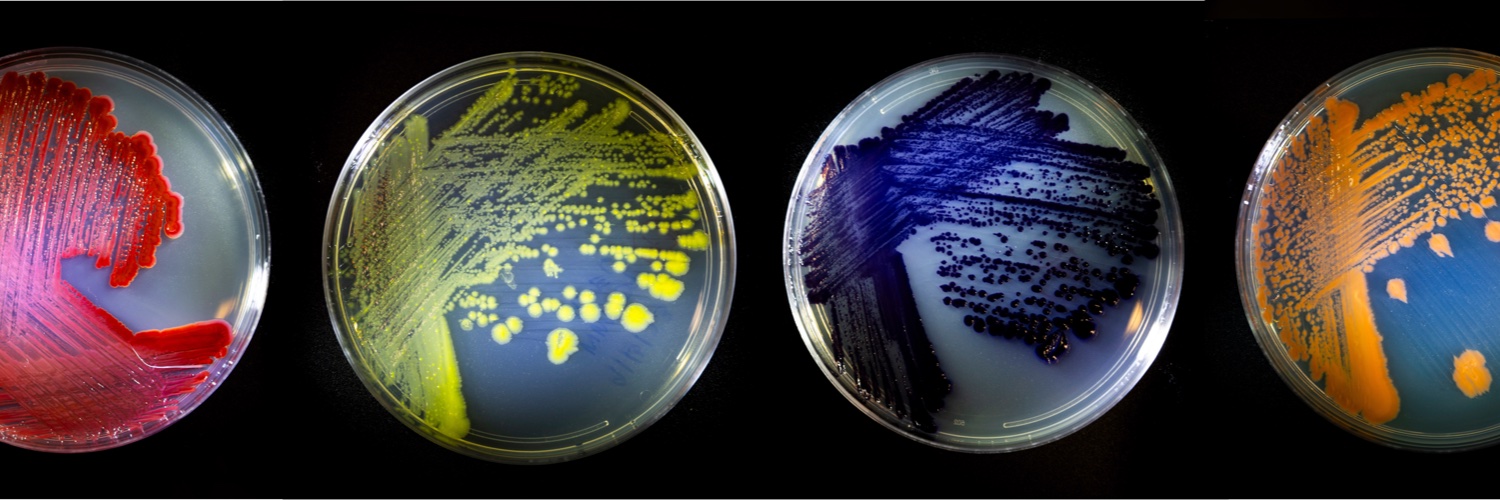
Wild Microbes banner

Wild Microbes retweetledi

(1/)Just published my last work from graduate school in the @geochurch lab, a project co-led with @TimWannier. We developed technology to simplify genome editing in diverse microbial species. pnas.org/doi/10.1073/pn…
English